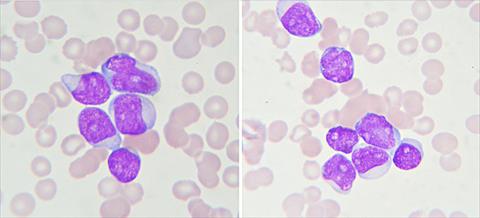

Νέα μελέτη δείχνει ότι οι προοπτικές επιβίωσης των ασθενών που πάσχουν από λευχαιμία και λέμφωμα στην Ευρώπη έχουν αυξηθεί σημαντικά. Οι...
Νέα μελέτη δείχνει ότι οι προοπτικές επιβίωσης των ασθενών που πάσχουν από λευχαιμία και λέμφωμα στην Ευρώπη έχουν αυξηθεί σημαντικά. Οι ασθενείς που αναπτύσσουν λέμφωμα ή λευχαιμία, έχουν σήμερα στις περισσότερες περιπτώσεις καλύτερες ευκαιρίες επιβίωσης από ό, τι στο τέλος του περασμένου αιώνα. Αυτό είναι το συμπέρασμα στο οποίο κατέληξαν επιστήμονες μετά από αξιολόγηση 30 μητρώων καρκίνου σε 20 ευρωπαϊκές χώρες, για το περιοδικό «The Lancet Oncology». Αναλύθηκαν τα δεδομένα των ασθενών που ήταν τουλάχιστον 15 ετών την εποχή της διάγνωσης και που έπασχαν από καρκίνο στους λεμφαδένες ή το αίμα. Για τις περισσότερες ασθένειες, η επιβίωση βελτιώθηκε σημαντικά μεταξύ των περιόδων 1997-1999 και 2006-08. Τα υψηλότερα ποσοστά αύξησης καταγράφηκαν στο διάχυτο μεγαλοκυτταρικό - Β λέμφωμα , στο οζώδες λέμφωμα, και στην χρόνια μυελογενή λευχαιμία και οξεία προμυελοκυτταρική λευχαιμία.